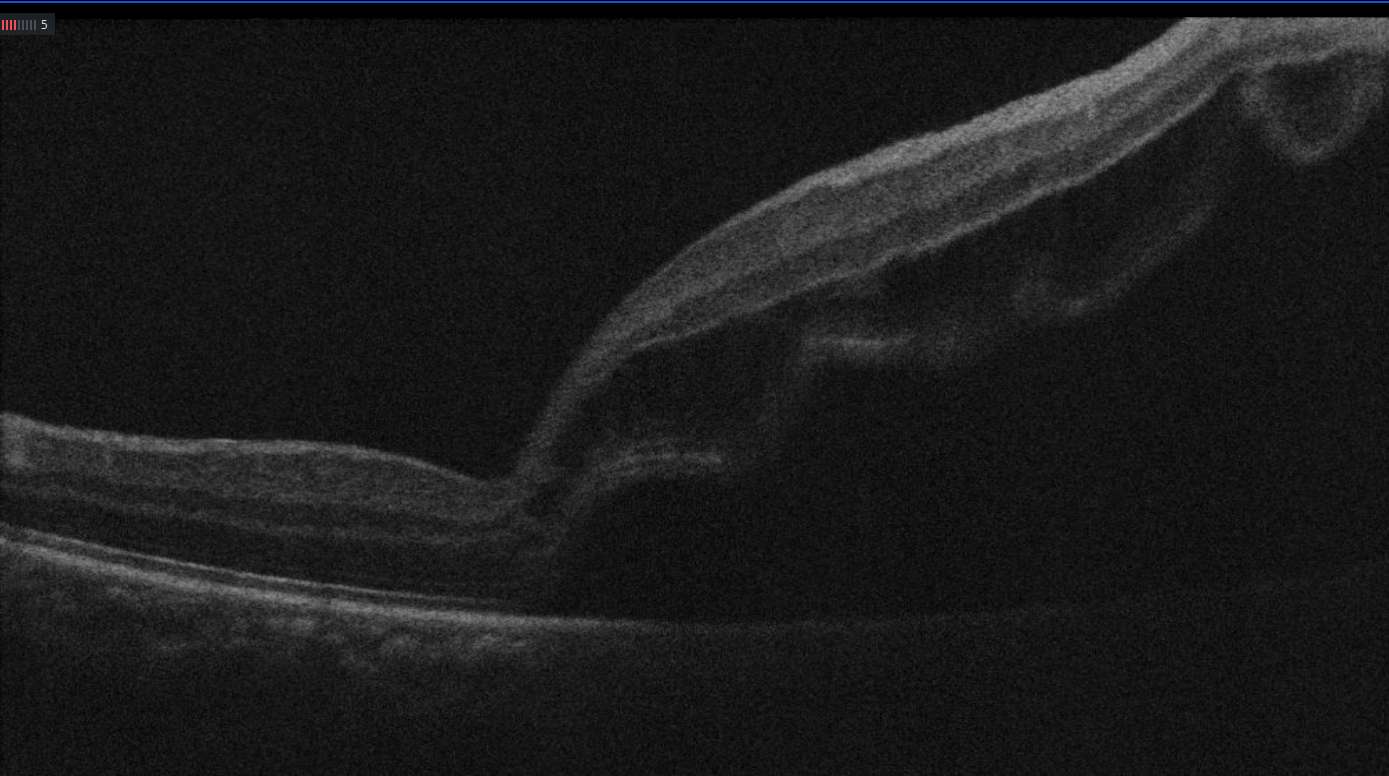

16岁,花一样的年纪,然而身为高中生的小陈突然感觉右眼视力骤然下降,眼前黑影笼罩,看东西扭曲变形。 作为一名高中生,小陈的视力突然“断崖式”下降,让小陈和家人的心都提到了嗓子眼。在其他医院检查后,他被诊断为“右眼视网膜脱离”,建议立刻转往上级医院。于是在朋友的推荐下,小陈的父亲带着他来到了龙岗区耳鼻咽喉医院。危急关头,一道“绿色通道”为他点亮了曙光,一场争分夺秒的“光明保卫战”就此打响。
小陈和父亲来到了龙岗区耳鼻咽喉医院刘清云主任的诊室,刘主任为小陈检查时发现右眼视网膜脱离的范围很大,在9点位-1点位视网膜青灰色隆起,累及黄斑区,中央动静脉随视网膜隆起、变形,12点位周边部视网膜见1个圆形裂孔,大小约0.1PD,10点至11点半周边部视网膜见视网膜格子样变性区。

因为视网膜脱离后,感光细胞会因缺血缺氧逐渐死亡,手术每延迟1天,视力恢复概率下降约10%。小陈的病情危急,视网膜脱离已然达到黄斑区,必须紧急手术,抢救视力。幸运的是,龙岗区耳鼻咽喉医院眼科开通的 “24小时孔源性视网膜脱离绿色通道”发挥了关键作用 。
刘清云主任考虑到患者很年轻,玻璃体尚未液化,凝胶状态完整,裂孔在视网膜周边,巩膜扣带术(外路法)不切除玻璃体,保持眼球内部的自然结构,对患者来说较为合适,从住院到手术,在短短的17小时内,刘主任为小陈完成了高难度的视网膜脱离复位术,术后第一天右眼的视网膜平伏,裂孔也已经封闭了,恢复良好,小陈和父亲悬着的心终于放下了。
这听起来很惊险,但究竟什么是“视网膜脱离”?“巩膜扣带术(外路法)”又是怎么回事?让我们一起了解一下。
一、视网膜:眼睛的“底片”

当这块至关重要的“底片”从眼球壁上脱落下来,就发生了视网膜脱离。一旦脱离,感光细胞会因失去营养供应而逐渐坏死,如果不及时处理,将导致视力严重、永久性的丧失。
二、为什么会脱离?“孔”是罪魁祸首
小明的诊断中有一个关键词——“孔源性”。这意味着视网膜脱离是因为视网膜先破了一个“洞”或“裂孔”。

1. 高度近视者:近视度数越高,眼球前后径被拉得越长,视网膜也随之变薄、变脆弱,就像被过度拉伸的气球壁,更容易出现破洞。
2. 年轻人、运动员:剧烈的外力撞击、对抗性运动(如篮球、足球),可能导致玻璃体(填充在眼球内的胶状物质)剧烈牵拉视网膜,从而产生裂孔。裂孔形成后,眼内的液体(液化玻璃体)会通过这个孔洞,钻到视网膜下面,就像墙纸起了泡,积水在后面越积越多,最终导致整片视网膜脱落。
三、治疗孔源性视网膜脱离的方法主要有两种
巩膜扣带手术(外路法)及玻璃体切除手术。
巩膜扣带手术(外路法):适用于年轻患者,玻璃体尚未液化,视网膜脱离尚新鲜,裂孔比较单一、明确的患者,手术通过在裂孔相应的眼球壁表面,用硅胶海绵或硅胶带向眼球内部顶压裂孔,从而封闭裂孔,促进视网膜复位。巩膜扣带手术优点在于对眼球的干扰比较小,其缺点在于可能改变屈光度,对复杂病例效果差。


刘清云主任生为小陈实施的 “巩膜扣带术(外路法)” ,是治疗孔源性视网膜脱离的一种经典且有效的方法。我们可以用一个生动的比喻来理解它:
想象一下,视网膜是墙纸,眼球壁是墙壁。现在墙纸破了个洞,并且脱落了。我们的目标是:把这个洞堵上,并把脱落的墙纸重新贴回墙上。
手术步骤如下:
1. 定位裂孔:医生会通过精密仪器找到视网膜上所有裂孔的确切位置。
2. 垫压与封堵:医生在眼球外部(巩膜上)对应裂孔的位置,缝合一小块特殊设计的硅胶块。这块硅胶就像给墙壁打了个“补丁”,它向内顶压眼球壁,使裂孔所在的区域变得平坦,并封闭裂孔。
3. 排出积液:医生会通过一个小切口,排出视网膜下的积液,为视网膜复位创造空间。
4. 冷凝加固:最后,医生会通过冷凝,在裂孔的周围进行“焊接”,使视网膜与眼球壁产生牢固的粘连,防止再次脱离。
整个手术是从眼球外部进行的,不进入眼内,因此相对安全,恢复也较快。
五、警钟长鸣:如何识别视网膜脱离的征兆?
小陈的病例给所有青少年,尤其是热爱运动的近视朋友们敲响了警钟。视网膜脱离并非毫无征兆,7一旦出现以下症状,必须立即就医:

· 频繁的闪光感(像闪电一样,尤其在暗处或转动眼球时);
· 视野中出现固定的黑影遮挡(像拉上了窗帘);
· 中心视力突然下降、视物变形。
请记住:这是眼科的急症!时间就是视力! 从出现症状到治疗,间隔时间越短,视力恢复的希望就越大。
结语
16岁的小陈是不幸的,但也是幸运的。他对症状的警觉和及时的医疗干预,成功地保住了视力。通过这个案例,我们了解了视网膜脱离的凶险,也认识了现代眼科医学如何通过精妙的手术化险为夷。保护心灵之窗,从了解疾病、警惕征兆开始。